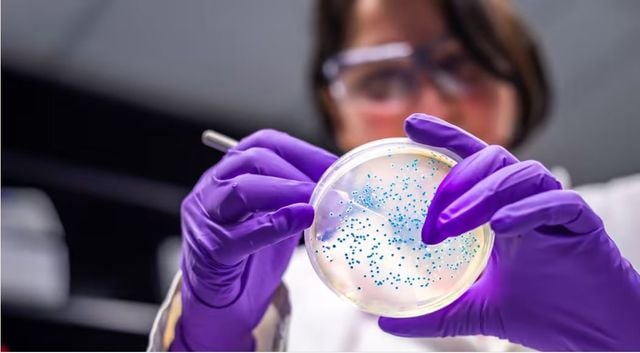

As we have discussed in recent posts, the UK Government has set its hopes for growth on becoming a ‘science superpower’. A key part of this agenda is to facilitate innovation, currently supported through various R&D tax reliefs. Continued focus on this area seems likely, as the opposition Labour Party have also placed R&D spending and innovation at the heart of their Industrial Strategy, as we discussed last year.
The UK Government has recently launched a consultation on its current R&D tax reliefs, citing a need to create simplicity, reduce fraud, boost overall innovation and ensure better value for the taxpayer. However, aspects of this may be a cause for concern for life sciences R&D companies.
- Current reliefs: The UK is slightly unusual in having two different systems to encourage innovation. The SME scheme is only available to smaller companies and provides a super-deduction against corporation tax (which loss-making companies can choose to surrender for a cash credit).
The RDEC scheme is primarily focused on larger companies and provides an “above-the-line” taxable credit. The SME scheme was historically more generous, although rates of the two schemes are being more closely aligned with effect from April 2023.
- Proposed reforms: At a high level, the Government is proposing to move towards a single system probably based on the RDEC scheme, although its consultation also seeks feedback on carrying over aspects of the SME regime.
There is a belief that the RDEC regime’s “above-the-line-credit” would help achieve overall tax simplification and make the credit more attractive and visible to investors and key decision makers.
It added that there was “merit to the case for further support” for R&D intensive SMEs and those in the life sciences previously in receipt of higher rate SME tax credits. Although such targeted support would need to be weighed alongside the implications in terms of complexity, funding and subsidy control.
- UK nexus: The reforms look to retain the measures previously consulted on to try and refocus “support towards innovation in the UK”, with exemptions including for activities that may be required to take place outside of the UK (such as clinical trials).
It also consults on whether and how the new regime should utilise the current PAYE/NICs based caps on claiming (designed to limit claims to entities with UK substance). This comes in the midst of the Government trying to make the UK a better place to conduct trials (we previously noted).
- Subcontracting: A key aspect of the consultation relates to how these reliefs interact with the use of subcontractors. The Government has broadly asked whether the customer or the subcontractor should be able to claim for the relevant work.
This is likely to have significant implications for life sciences companies, who often rely on CROs and CMOs to conduct their activities. We expect significant dealmaking in this area during 2023 (as discussed previously), and so this may have consequences for larger investors as well.
- Next steps: The consultation runs until 13 March 2023. The Government noted that any revised scheme would come into effect from April 2024 and that the final rates of relief will not be consulted on.
Ropes & Gray will be involved in preparing responses to this consultation, so please get in touch if you require any assistance with this process.
Authors
Stay Up To Date with Ropes & Gray
Ropes & Gray attorneys provide timely analysis on legal developments, court decisions and changes in legislation and regulations.
Stay in the loop with all things Ropes & Gray, and find out more about our people, culture, initiatives and everything that’s happening.
We regularly notify our clients and contacts of significant legal developments, news, webinars and teleconferences that affect their industries.